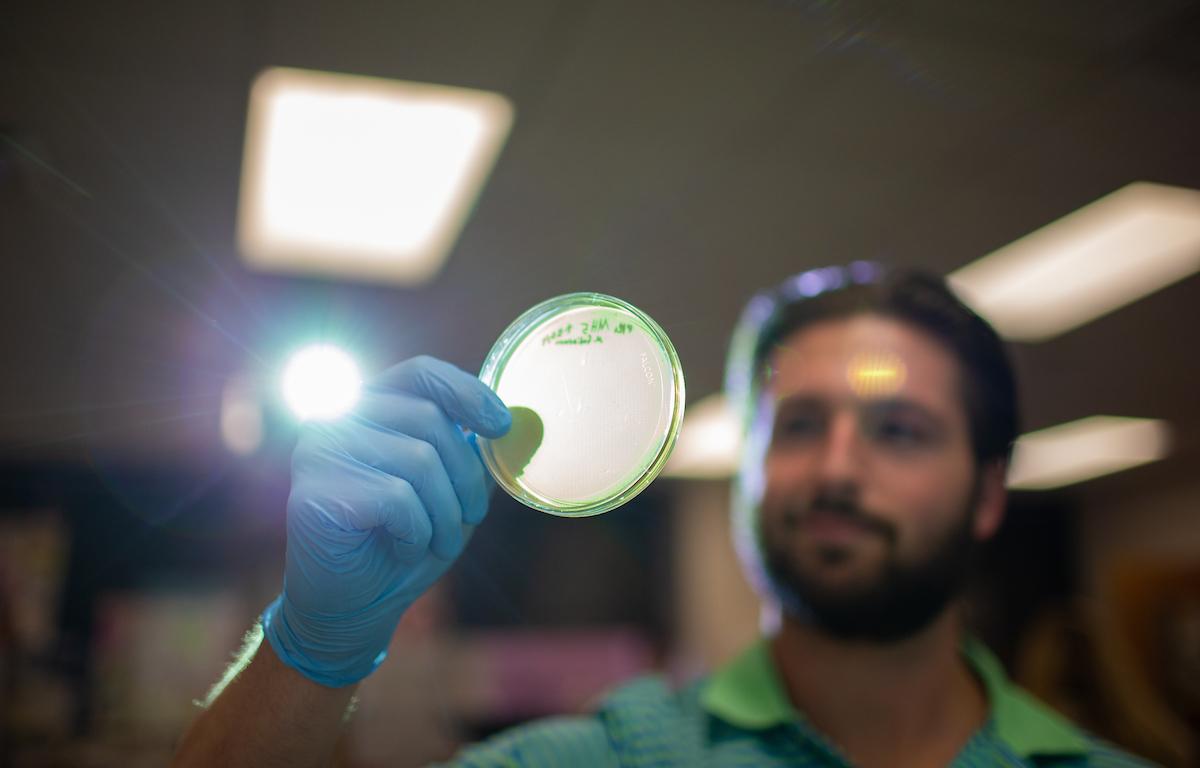

CLARKSVILLE, Tenn (CLARKSVILLENOW) – This semester, 10 Austin Peay State University students in Dr. Sergei Markov’s junior- and senior-level biology class are taking advantage of a unique research opportunity that could help lead to medical breakthroughs.
They’re participating in Science Education Alliance-Phage Hunters Advancing Genomics and Evolutionary Science (SEA-PHAGES), a yearlong laboratory course in which students discover, isolate and analyze bacteria-infecting viruses called bacteriophages. The bacteriophages more commonly are called phages, and the students are phage hunters.
The program’s goal is simple: Increase undergraduate interest and retention in the biological sciences through research immersion. Several thousand college students join the program each year, and their research goes into a massive genome bank. That bank has helped scientists find new ways to treat patients with debilitating bacterial infections.
“It’s a great opportunity for Austin Peay and its students to be a part of a huge experiment,” said Jerry Reed, a graduate student helping Markov with the classes. “By charting those genes, by looking at that DNA, the better we’re able to manipulate the phages for our own benefits, such as medical research.”
Markov’s students benefit more directly, however, by getting valuable research experience.
“To get an advanced degree, you need to do research,” Markov said. “That’s what I tell students coming to this class is they will get that research experience. They’re going to find phages, isolate the phage, analyze it, name it. We’re going to sequence and analyze its DNA.”

‘We just started digging in the dirt’
Phages are bacteria-killing viruses. They’re harmless to humans, and scientists can study them easily. They’re everywhere. More than a nonillion phages – that’s 1 followed by 30 zeroes – exist on Earth in dirt, water and air. Markov’s students gathered their phages from dirt they found on campus.
The SEA-PHAGES program asks its student researchers to collect as many phages as they can, examine them under a microscope, sequence their genome and test the phages’ ability to fight bacteria. Phages are so diverse that students often discover and name their own phage. SEA-PHAGES hunters have identified more than 8,000 phages since 2008.
Sarah Binkley, a junior studying microbiology, found her phage in a clump of dirt by Harned Hall.
“We just went outside and started digging in the dirt,” she said.
The hands-on research attracted Binkley to the program.
“You get a lot of pride and accomplishment when you succeed at it,” Binkley said. “This is something I found myself. I’m not repeating someone else’s experiment with their virus. This is my own virus.”

‘I get to publish my own paper’
Junior biology major Gabrielle Rueff found her dirt sample near the Marks Building.
“You learn all this stuff in BIO I and BIO II, and in this class, you get to apply what you learned, and you get to see immediate results the next class period,” she said. “There’s this virus that is infecting this bacteria, and you have these little clear spots (in the Petri dish) where that virus has killed off that bacteria.
“In traditional classrooms, you don’t get to see that firsthand,” she added.
Markov’s class has to “grow” enough of the phages to isolate the phage DNA and submit it to Howard Hughes Medical Institute’s (HHMI) science education division for sequencing. The students also will capture a photo of the phage using an electron microscope and could present their research at a conference next summer.
That excites Rueff. “Once we harvest our DNA and we send it off to be sequenced, that’s when I get to publish my own paper.”
During the spring semester, Markov’s students will analyze the data HHMI returns.
“We need to find what kind of genes are in the DNA and compare them to other phages,” he said.

‘I’d be happy even if it’s not mine’
Using phages to fight bacteria is an idea that’s been around for decades. The rise of antibiotic resistance has increased interest in using phage therapy to fight diseases.
HHMI – which partners with the University of Pittsburgh in the SEA-PHAGES program – announced earlier this year the program used phage therapy to fight a bacterial infection in a 15-year-old girl.
The antibiotics she had used for eight years to fight off lung infection weren’t working as well. The scientists used genetically engineered phages to attack and reverse the infection. The SEA-PHAGES program revealed the viruses that could help. You can read more about this case – and get a good background on SEA-PHAGES – by clicking here.
Markov’s students know their research will add to this knowledge.
“There are a lot of therapeutics and different medications that are going to come out of it,” Rueff said. “I’m really excited about the future of science.”
Binkley added: “Once it starts taking off more, the potential for what we can find and discover and the problems we can solve with it is just really cool to me.
“I hope this research will be beneficial in the future, that we get real progress in medicine or some other field,” she said. “I’d be really happy even it’s not mine.”